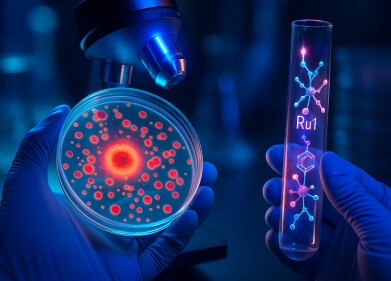

-
 Boulby Underground Laboratory (Credit: STFC)
Boulby Underground Laboratory (Credit: STFC)
Research news
Work begins on International project to detect dark matter
Oct 07 2024
UK researchers have started on the design of a new device and components to detect dark matter particles thought to make up more than 85% of the content of the Universe, as part of the world-leading Xenon Lux-Zeplin (XLZD) Consortium’s plans to construct the world’s most advanced dark matter detector.
A preliminary award of £8 million from the UK Research and Innovation (UKRI) Infrastructure Fund is supporting a partnership of 14 UK universities, led by Imperial College London, to work with the Science and Technology Facilities Council (STFC) over the next three and a half years at its Boulby Underground Laboratory which might also become the host site for this international experiment.
The detector will consist of a large underground ‘thermos flask’ containing up to 100 tonnes of liquid xenon, which scientists believe will react subtly with dark matter as it passes through the earth. The presence of dark particles will generate tiny, but detectable, flashes of light that wil be recorded and analysed. As well as exploring the fundamental laws of physics, the XLZD observatory will also act as a telescope for the nature and composition of our Universe, searching for dark matter particles and new neutrino physics.
Professor Sean Paling, Director and Senior Scientist at STFC’s Boulby Underground Laboratory said: “To discover, or even be able to rule out the existence of dark matter, will be an enormous leap for science and transform our understanding of the cosmos.
“We are now closer than ever to achieving this and as long as we can come together as an international community, invest in the right instruments and remain focused on our search, there are potential big breakthroughs just around the corner.
The XLZD experiment is the clear next step for dark matter research and will also be an important instrument for understanding wider fundamental questions about the content of our Universe. I’m delighted that Boulby, Imperial and all contributing UK institutions are playing this key role in making it a reality.”
UK project leader Professor Henrique Araújo, from Imperial College London, welcomed the news:” Several underground laboratories around the world are bidding to host our experiment; this is fantastic ‘discovery science’, using the leading technology which we helped pioneer in the UK – and this development project is critical to position the UK to host. We must now show that this is viable.
“If the project is hosted at Boulby, this will be among the largest and most significant UK-based science projects in over 50 years, attracting international scientists to the north-east region.
More information online
Digital Edition
Lab Asia Dec 2025
December 2025
Chromatography Articles- Cutting-edge sample preparation tools help laboratories to stay ahead of the curveMass Spectrometry & Spectroscopy Articles- Unlocking the complexity of metabolomics: Pushi...
View all digital editions
Events
Jan 21 2026 Tokyo, Japan
Jan 28 2026 Tokyo, Japan
Jan 29 2026 New Delhi, India
Feb 07 2026 Boston, MA, USA
Asia Pharma Expo/Asia Lab Expo
Feb 12 2026 Dhaka, Bangladesh